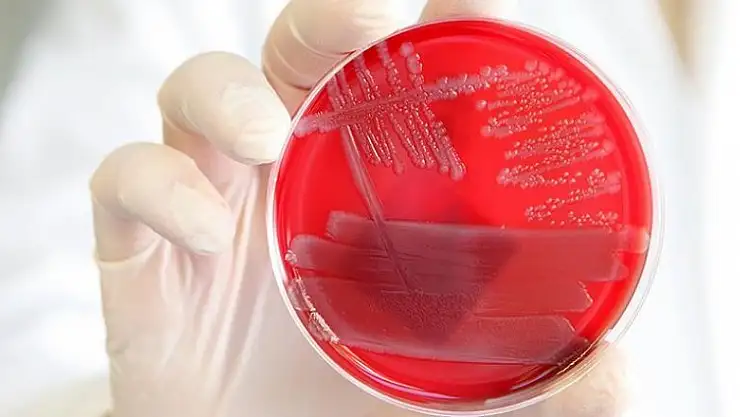

Bazı virüsler kadınları erkeklerden daha az etkiliyor
Bazı virüslerin kadınları erkeklerden daha az etkilediği, bunun, virüslere daha fazla yayılma imkanı sunan kadınların 'kıymetli taşıyıcılar' olmasından kaynaklanabileceği bildirildi.
Royal Holloway Üniversitesinden bilim adamları Francisco Ubeda ve Vincent Jansen, matematiksel modelleme kullanarak, virüslerin, anneden çocuğa geçme olasılığı var olduğu sürece kadınları daha az etkilediğini ortaya koydu.
Sonuçları New Scientist dergisinde yayımlanan araştırmada, erkeklerin veremden ölme olasılığının kadınlardan bir buçuk kat fazla olduğu, insan papillom virüsü taşıyan erkeklerin kadınlardan beş kat fazla kansere yakalandığı, yine Epstein-Barr virüsü bulaşan erkeklerde, Hodgkin lenfoma hastalığının kadınlardan iki kat fazla görüldüğü örnekleri verildi.
Bu özelliğin, insan t hücreli lösemi virüsünün, Japonya'da erkeklerde kadınlardan daha fazla kansere dönüşürken, Karayipler'de böyle farkın görülmemesiyle ilgili soru işaretine de ışık tuttuğu belirtildi. Bilim adamları, Japonya'daki kadınların bebeklerini Karayipli kadınlardan daha uzun ve yaygın biçimde emzirdiğini, bunun da virüse, bir diğer taşıyıcıya bulaşma fırsatı verdiğini ifade etti.
Araştırmacı Vincent Jansen, virüsün, bulaştığı kişinin kadın ya da erkek olduğunu, hormonal ve diğer metobolik farklılıklar sayesinde tespit edebileceğini belirtti.
Bakmadan Geçme